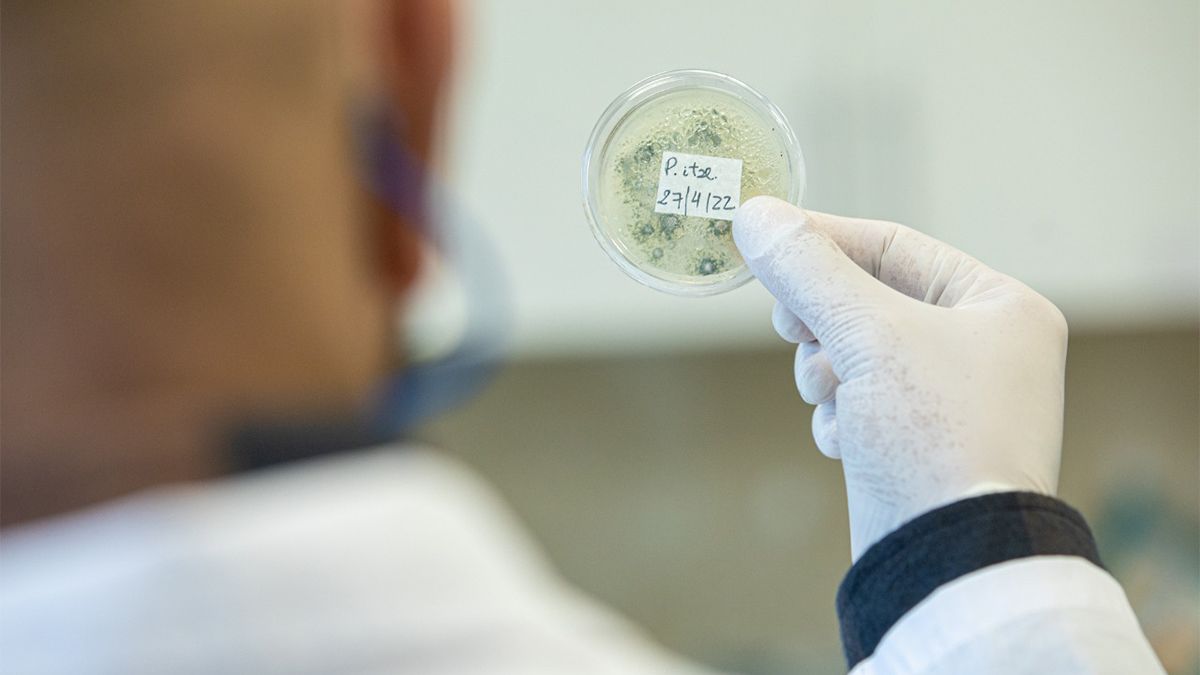
El título del proyecto es ‘Evaluación y desarrollo de variedades de Cannabis para uso medicinal’.

Cannabis medicinal: la UNL y el Conicet trabajan en el mejoramiento genético de semillas
Buscan desarrollar un semillero de cannabis medicinal de última generación, preparado para satisfacer las necesidades de un mercado que crece a nivel local.
Una investigación que se está desarrollando en el Instituto de Ciencias Agropecuarias del Litoral (Iciagro Litoral) de la ciudad de Esperanza, posiciona al Consejo Nacional de investigaciones Científicas y Técnicas (Conicet) y la Universidad Nacional del Litoral (UNL) a la vanguardia del desarrollo genético de semillas de cannabis para uso medicinal. El innovador estudio, que fue aprobado recientemente por el Ministerio de Salud de la Nación y cuenta con aportes de la empresa santafesina Enersit SA, es llevado adelante por investigadores e investigadoras Conicet-UNL nucleados en el Iciagro Litoral y la Facultad de Ciencias Agrarias (FCA). Uno de los objetivos de la iniciativa es desarrollar en esta región de la provincia de Santa Fe un semillero de cannabis medicinal de última generación, preparado para satisfacer las necesidades de un mercado que crece a nivel local.
Te podría interesar
Investigación vanguardista
El título del proyecto ‘Evaluación y desarrollo de variedades de Cannabis para uso medicinal’ se lleva adelante bajo la dirección y codirección de Marcelo Zabala y Marcos Derita, con la participación de Carlos Dezar, Geraldine Richard y Silvia Imhoff en el marco de un convenio de I+D con la empresa Enersit.
“Dadas las capacidades tecnológicas instaladas en el Instituto y FCA, donde hay un grupo que trabaja en mejoramiento de plantas y otro grupo que trabaja en la extracción y elaboración de productos naturales a base de plantas, generamos este convenio que busca, por un lado, ver la adaptación de variedades de cannabis en el cordón hortícola santafesino -nuestra hipótesis es que es una zona apta para este cultivo, ya que es intensivo- y, por otro lado, empezar a desarrollar cruzamientos entre diferentes materiales genéticos con el objetivo de generar diversas variedades de cannabis”, explicó Marcelo Zabala, integrante del grupo REFINA (Recursos Fitogenéticos Nativos) del Iciagro Litoral y docente de la FCA. En este sentido, el investigador aseguró que “la industria del cannabis a nivel nacional requiere de mucho estudio y desarrollo, cosa que actualmente no existe en la Argentina y es lo que estamos llevando adelante mediante este proyecto. Además, haremos evaluaciones claves para la región, para ver dónde es mejor cultivar cannabis y desarrollar semillas mejoradas genéticamente para favorecer su adaptación”.
Por su parte, Marcos Derita, investigador del grupo PyP (Producción y Protección Vegetal) del mencionado instituto, explicó que “en cuanto a la investigación en torno a cannabis medicinal, desde el Laboratorio de Productos Bioactivos y Aplicaciones Agrosustentables de Iciagro Litoral, complementaremos el trabajo desarrollado por el grupo REFINA determinando la composición de los aceites que se extraen de plantas producidas a partir de las semillas mejoradas genéticamente. Se analizará en los aceites de cannabis la composición ‘sufito canabinoide’ que es fundamental a la hora de determinar su uso medicinal. Finalmente, Derita coincidió con Zabala en que “este es un tema de estudio de absoluta necesidad y vacancia a nivel regional y nacional, tanto en Conicet como de las Universidades”.
Articulación público-privada
El desarrollo de esta investigación está vinculado a un convenio rubricado en 2021 por la presidenta de Conicet, Ana Franchi; el rector de la UNL, Enrique Mammarella; y el presidente de ENERSIT SA, Leonardo Simonutti.
El acuerdo, denominado “Evaluación y desarrollo de variedades de Cannabis para uso medicinal”, constituye un plan de trabajo de I+D que llevarán adelante equipos de investigación pertenecientes al Iciagro Litoral (Conicet-UNL) y, a su vez, implica la construcción de obras de infraestructura en el predio de la Facultad de Ciencias Agrarias de la Universidad Nacional del Litoral, ubicada en la ciudad de Esperanza (Santa Fe).
El convenio se propone realizar una evaluación de las variedades genéticas de cannabis medicinal para identificar aquellas que mejor se adapten al cordón hortícola santafesino; realizar la caracterización de principios activos; y obtener, en base al uso de técnicas de mejoramiento agronómico, nuevas variedades de las semillas.
Para desarrollar el proyecto se cuenta, además del personal y el equipamiento adecuado, con una cámara de cultivo y parcelas de uso experimental de aproximadamente 750 m2. Para realizar la extracción de aceites de las plantas se utilizarán las instalaciones del laboratorio de productos naturales, bioactivos y aplicaciones agrosustentables del Iciagro Litoral.
Aval nacional
En julio de este año, el proyecto logró la aprobación del Ministerio de Salud de la Nación (Resolución 1433/2022), requisito sine qua non para el desarrollo de actividades que involucren la producción del cultivo de cannabis y la obtención de productos derivados, de acuerdo con la Ley 27.350 que establece el marco regulatorio para la investigación médica y científica del uso medicinal terapéutico o paliativo del dolor de la planta de cannabis y sus derivados.
“El aval del Ministerio Nacional de Salud, específicamente del Programa Nacional de Cannabis, para el estudio y la investigación de la planta de cannabis para uso medicinal implica que a partir de ahora podemos comenzar a desarrollar los estudios”, aseguró la directora del Iciagro Litoral, Silvia Imhoff, y agregó: “podemos comenzar a producir plantas a partir de las cuales se harán los cruzamientos correspondientes para luego obtener los aceites se van a evaluar, tratando de encontrar variedades de semillas que produzcan los mejores aceites y se adapten a nuestra zona, particularmente al cordón hortícola, que necesita hacer rotación de cultivos”.
Iciagro Litoral
El Instituto de Ciencias Agropecuarias del Litoral fue creado a fines del año 2018 por el trabajo conjunto de investigadores de Conicet y Docentes-Investigadores de la Facultad de Ciencias Agrarias de la UNL, donde tiene su sede. Ocupa una posición estratégica por su influencia sobre una amplia región que abarca el centro-norte de Santa Fe, el este de Córdoba, el sureste de Santiago del Estero y sur de Chaco. Esta amplia zona contiene parte de las ecorregiones del Espinal Periestépico, Chaco Húmedo, Chaco Seco y del Delta e Islas del Paraná, y se caracteriza por la diversidad de sistemas productivos: agrícolas, agrícolaganaderos, ganaderos y silvo-pastoriles.
Contando con un equipo de 26 investigadores e investigadoras, 3 miembros de la carrera del personal de apoyo, 50 becarios y becarias y personal administrativo, el Instituto se aboca a generar conocimiento científico y aplicado en las diversas áreas disciplinares de las ciencias agropecuarias, promoviendo, además, la innovación productiva y organizacional en los sistemas agroalimentarios.
Racme
La Red de Cannabis y sus usos medicinales (Racme), fue impulsada y coordinada por la científica del Conicet Silvia Kochen. Realiza -desde el año 2020- un trabajo en conjunto con investigadores e investigadoras en materia de cannabis medicinal, que aborda en comisiones de trabajo los siguientes puntos: la cuestión de la producción; la reglamentación de la Ley 27350; la investigación clínica; la investigación básica; el control de calidad; y de cómo comunicar sobre cannabis derribando los prejuicios instalados alrededor de la planta.
FUENTE: UNL